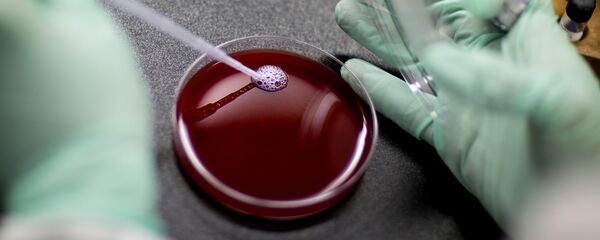
مختبر الدم - سبوتنيك عربي

رصد موقع "thefactsite" قائمة بأغلى 10 ساعات في العالم والتاريخ، وجاءت القائمة كالتالي:
1- 26 مليون دولار — "Chopard 201-carat watch"
تحتوي على 874 قطعة من الماس النادر، وتم بيعها في عام 2000 مقابل سعر مخيف يبلغ 25 مليون دولار أمريكي، وهي الأغلى فى العالم، وتم تصنيع 5 نسخ منها فقط.
2- 11.1 مليون دولار — "Patek Philippe Ref. 1518"
تأتي ضمن فئة الساعات الفاخرة، وتتميز بالرقي رغم بساطة تصميمها، وتحتوي على غلاف من الفولاذ القوي المقاوم للصدأ بدلًا من الذهب، وتم تصنيع 4 نسخ منها فقط حول العالم.
3- 5 ملايين دولار — "Hublot Big Bang"
تحتوي على 1280 من الماس عيار 3 قيراط، ويستغرق تصنيعها عاما كاملًا لجمع قطع الماس من حول العالم.
4- 4 ملايين دلار — "Patek Philippe Platinum World Time"
تأتي مغطاة بالكامل بالبلاتينوم وتم تصنيعها في عام 1939، ومصممة على خريطة العالم، وأعيد بيعها في مزاد علني عام 2002، وكانت حتى هذا الوقت الأغلى في العالم، حتى تجاوزها في القيمة 8 ساعات أخرى.
5- 3.7 مليون دولار — "Patek Philippe 5004T"
وهي من ماركة "باتيك فيليب" الشهيرة، ومغطاة من الخارج بالتيتانيوم، ومزودة بكرونوجراف دقيق يحسب الوقت والتوقيتات، والسرعة والمسافات، وتم تصميمها يدويا في عام 2013 في نسخة واحدة فقط نادرة حول العالم.